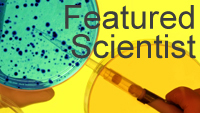

Academics
The study of the ecological and evolutionary mechanisms that give rise to the spatial and temporal dynamics of populations and species is one of the most exciting and rapidly advancing areas of modern science. The general field of Population Biology integrates biological mechanism across many levels of organization, from the molecular forces leading to the evolution of genome organization to large interconnected networks of species in complex ecological systems. Scientists in this challenging area must consequently cross the normal boundary lines dividing traditional disciplines and employ complex, multidisciplinary approaches to begin to understand the evolution, organization and dynamics of natural populations.
The graduate program in Population Biology, Ecology, and Evolution provides the multidisciplinary training required for a successful research and teaching career. The program allows the student to learn currently accepted scientific facts and theories; learn to plan, conduct and critically evaluate experiments; make an original contribution to scientific knowledge; become skilled in oral and written communication; and become self-sufficient in continuing education beyond graduate school. The program also prepares the student to teach Population Biology, Ecology, and Evolution and related disciplines in professional and graduate schools.
Graduate training in the Program in Population Biology, Ecology and Evolution is research-focused and differs considerably from undergraduate or professional school. The formal course work is intended to provide basic knowledge as well as guidance for self-education by the student scholar. Such self-education is a full-time job and must be an active, rather than passive, process. Much of graduate teaching consists of individualized instruction between students and their advisors, in an atmosphere of cooperative research and discovery.
Students should consider the graduate training program as the beginning of their professional careers, rather than as an extension of schooling as they have known it. The graduate student does many of the same things that occupy professional scientists: reading scientific literature; planning, conducting, and analyzing experiments; and writing grant proposals and publishing papers. The earlier the student becomes proficient at these endeavors, the sooner and further his or her career will progress. Scientific research can be discouraging at times and a great deal of inertia sometimes must be overcome to bring a project to conclusion. However, the rewards to the dedicated student include a sense of accomplishment, independence, and discovery as well as entry into a challenging profession.